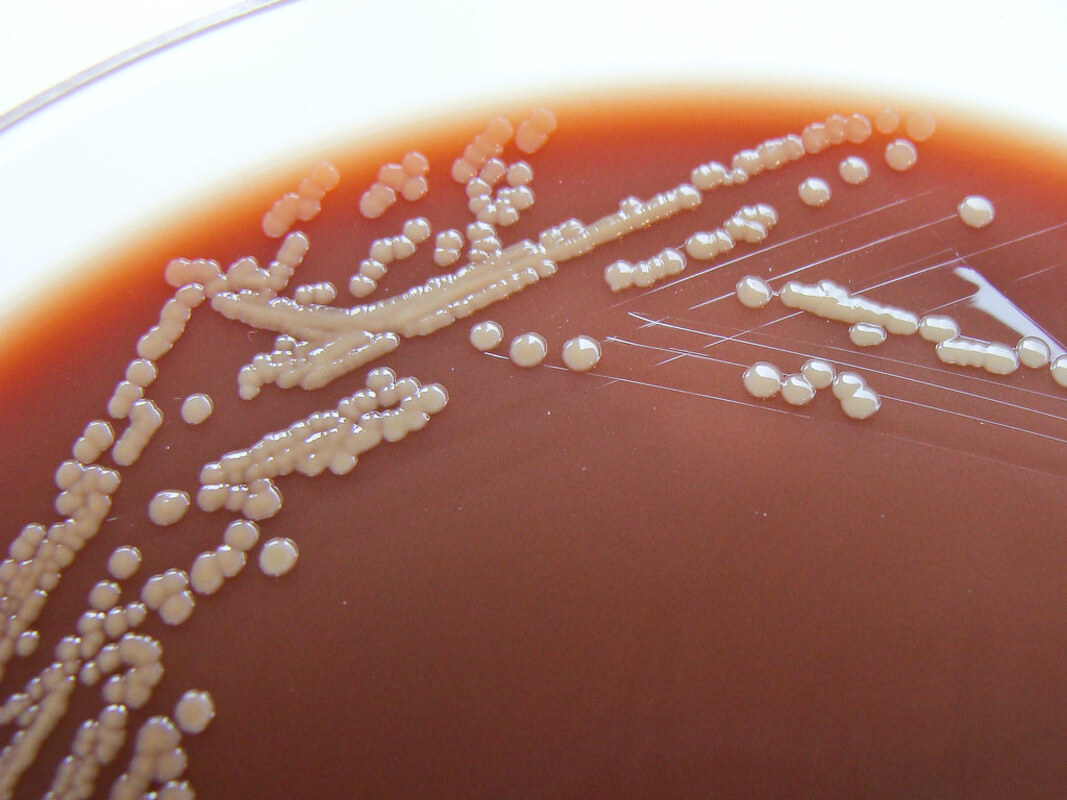
Виды Neisseria связывают с ухудшением бронхоэктазов у пациентов

Международная группа ученых обнаружила, что нейссерии могут вызывать инфекции у пациентов с бронхоэктазами, астмой и хронической обструктивной болезнью легких (ХОБЛ).
В исследовании, опубликованном вчера в журнале Cell Host & Microbe, представлены убедительные доказательства того, что виды Neisseria могут вызывать заболевания легких и связаны с ухудшением протекания бронхоэктазов у пациентов.
Бронхоэктазы - это длительное заболевание, при котором дыхательные пути легких становятся аномально расширенными, что наблюдалось у 50 % сингапурских пациентов. Это заболевание в четыре раза более распространено среди жителей Азии по сравнению с западными людьми, а также может возникать после выздоровления от туберкулеза. В Сингапуре в ходе исследования было описано 420 случаев госпитализации пациентов с бронхоэктазами в 2017 году. Показатель заболеваемости составил 10,6 на 100 000 человек и сильно увеличивался с возрастом.
Несмотря на распространенность этого заболевания среди пожилых людей, в большинстве случаев не удавалось найти причину развития бронхоэктазов, и заболевание, как правило, возникало спонтанно. Чтобы разгадать загадку, почему бронхоэктазы значительно чаще обостряется у пожилых азиатских пациентов, группа международных исследователей под руководством Санджая Чотирмалла, сопоставила данные о заболеваниях и инфекциях 225 пациентов с бронхоэктазами азиатского (Сингапур и Малайзия) происхождения с данными пациентов с бронхоэктазами в Европе.
Хотя хорошо известно, что виды Neisseria вызывают менингит и гонорею, они не инфицируют легкие. Благодаря детальной идентификации и тщательной характеристике, исследовательская группа обнаружила, что нейссерии доминировали в микробиоме азиатских пациентов с обострением бронхоэктатической болезни. В частности, у пациентов с бронхоэктазами с преобладающим количеством вида Neisseria subflava, наблюдались более тяжелые заболевания и реинфекции по сравнению с пациентами с бронхоэктазами без такого высокого количества Neisseria. После дальнейшего исследования с использованием экспериментальных клеточных и животных моделей исследовательская группа подтвердила, что N. subflava вызывает разрушение клеток, что приводит к воспалению и иммунной дисфункции у пациентов с бронхоэктазами, инфицированных этой бактерией. До этого открытия Neisseria не рассматривались как причина легочной инфекции или тяжелой формы заболевания у пациентов с бронхоэктазами.
"Наши результаты впервые установили, что худшие клинические результаты, такие как большая тяжесть заболевания, худшая функция легких и высокая частота повторных инфекций среди пациентов с бронхоэктазами, тесно ассоциированы с бактериями Neisseria, и что это открытие особенно важно для пациентов из Азии", - сообщил Чотирмалл. "Это открытие имеет большое значение, потому что оно может изменить то, как мы лечим пациентов с бронхоэктазами. Врачи теперь должны будут думать о Neisseria как о потенциальной причины ухудшения состояния пациентов и проводить тесты для выявления тех, кто может быть носителем этого вида бактерий в своих легких. Мы надеемся, что ранняя идентификация приведет к персонализированной терапии и, следовательно, к улучшению исходов болезни для азиатских пациентов с этим разрушительным заболеванием".
Помимо связи между нейссериями и тяжелой формой бронхоэктаза, исследовательская группа также обнаружила присутствие этих бактерий при других более распространенных хронических респираторных заболеваниях, таких как тяжелая астма и ХОБЛ. Используя технологии секвенирования следующего поколения, авторы также попытались выяснить, откуда может происходить эта бактерия, и отобрали пробы в домах пациентов с бронхоэктазами с высоким количеством Neisseria в легких. Исследователи обнаружили присутствие бактерии в домашней среде, предположив, что внутреннее жилое пространство и, возможно, тропический климат могут способствовать присутствию этой бактерии.
"Отрадно видеть, что мы продвинулись в определении бактерий Neisseria как причины обострения бронхоэктазов - виновника, который первоначально не рассматривался как угроза. Это является убедительным напоминанием о том, что мы должны проявлять больше инициативы в изучении различных причин, поскольку каждый, казалось бы, невинный фактор может быть источником угрозы для нашего организма и здоровья в целом", - отметил Чотирмалл. "Трансляционный подход, принятый в этой работе, имел решающее значение для нашего успеха. Начав с "постели больного", мы работали в ретроспективном направлении, чтобы раскрыть процесс распространения бактерий. Благодаря междисциплинарному характеру исследования, наша группа смогла взаимодействовать с представителями различных научных дисциплин, что обеспечило интересный опыт и позволило получить уникальные знания о заболевании".
Исследователи намерены провести дальнейшие клинические испытания по элиминации Neisseria из микробиома в рамках недавно созданного Центра микробиомной медицины, который стремится оценить преимущества направленного воздействия на Neisseria и антибиотикотерапии при первом обнаружении, в надежде, что это приведет к улучшению клинических результатов для пациентов с хроническими респираторными заболеваниями.